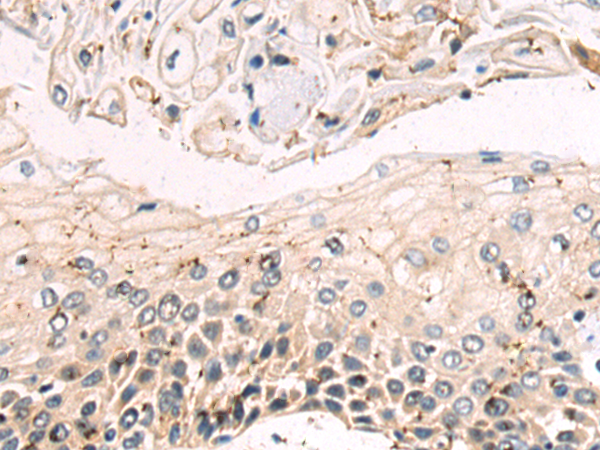

-
分类: 科研抗体货号: P09652别名: MIR1; GLFND应用: WB,IHC反应种属: Human, Mouse
-
分类: 科研抗体货号: P09637别名: p10; PCH1B; RRP40; Rrp40p; CGI-102; hRrp-40; bA3J10.7应用: IHC反应种属: Human, Mouse
-
分类: 科研抗体货号: P09619别名: FAM31B; C1ORF18; C1orf218应用: WB反应种属: Human, Mouse
-
分类: 科研抗体货号: P09651别名: L1MT; BM022; MRP-L1应用: WB,IHC反应种属: Human
-
分类: 科研抗体货号: P09636别名:应用: WB反应种属: Human, Mouse, Rat
-
分类: 科研抗体货号: P09618别名: FAM31A; KIAA1608应用: IHC反应种属: Human
-
分类: 科研抗体货号: P09650别名: XIB; G4.8; DNL1L; DNASEX; DNAS1L1应用: WB,IHC反应种属: Human
-
分类: 科研抗体货号: P09635别名: PDIA8; C12orf46应用: IHC反应种属: Human
-
分类: 科研抗体货号: P09617别名: FAM31B; C1ORF18; C1orf218应用: IHC反应种属: Human, Mouse
-
分类: 科研抗体货号: P09649别名: RC68; INT11; RC-68; CPSF3L; CPSF73L应用: IHC反应种属: Human, Mouse, Rat

鄂公网安备42018502007531号
鄂公网安备42018502007531号

